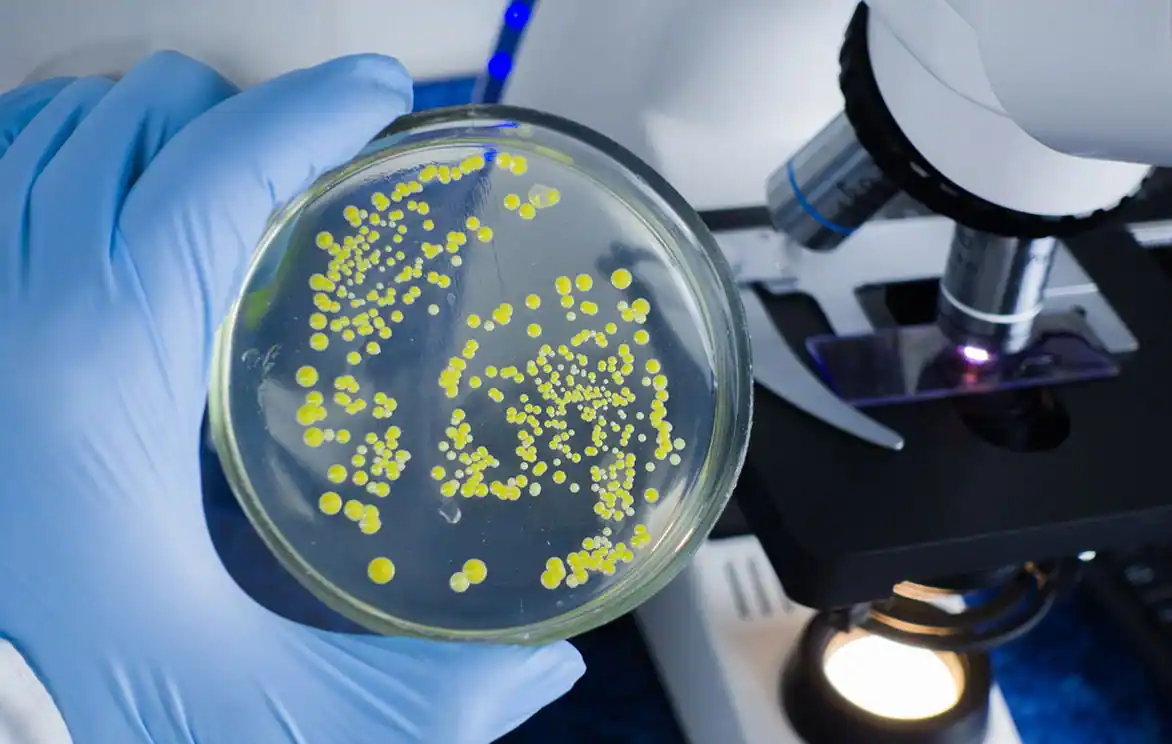
Koliform Bakteri

SteriPlus® Klordioksit 30 Litre
₺10.050,00 Orijinal fiyat: ₺10.050,00.₺6.150,00Şu andaki fiyat: ₺6.150,00. KDV Dahil

SteriPlus® Klordioksit 5 Litre
₺1.675,00 Orijinal fiyat: ₺1.675,00.₺1.450,00Şu andaki fiyat: ₺1.450,00. KDV Dahil
- Sağlık Bakanlığı Onaylı
- 6 Ay Raf Ömrü
Stok kodu:
40757-IBC
| Miktar | IBC |
|---|---|
| Raf Ömrü | 6 Ay |
₺105.000,00 KDV Dahil
256 Bit Güvenli Ödeme
Açıklama


SteriPlus® Kloridoksit Sağladığı Avantajlar
Türkiye dahil birçok ülkede patentli olan CHEMYA Klordioksit, sadece lejyonella gibi tehlikeli bakterilere karşı değil, aynı zamanda benzersiz avantajlar sunan kullanım özellikleriyle dikkat çekmektedir.
Klordioksit, geniş bir pH aralığında etkilidir ve çevreye uyumlu olduğu için her türlü su şartlandırması için güvenle kullanılabilir.
Saklama koşullarına uyulduğunda, aktif solüsyonun etkinliği yaklaşık 12 ay boyunca devam eder.
-
Etkili
-
Dayanıklı
-
Güvenilir
-
Konsantre
-
Standardize
-
 Bakanlık Onaylı
Bakanlık Onaylı
Kullanım Alanları
Türkiye dahil birçok ülkede patentli olan CHEMYA Klordioksit, sadece lejyonella gibi tehlikeli bakterilere karşı değil, aynı zamanda benzersiz avantajlar sunan kullanım özellikleriyle dikkat çekmektedir.
Klordioksit, geniş bir pH aralığında etkilidir ve çevreye uyumlu olduğu için her türlü su şartlandırması için güvenle kullanılabilir.
Saklama koşullarına uyulduğunda, aktif solüsyonun etkinliği yaklaşık 12 ay boyunca devam eder.
-
Hayvan Yetiştiriciliği
-
Dayanıklı
-
Güvenilir
-
Konsantre
-
Standardize
-
 Bakanlık Onaylı
Bakanlık Onaylı
Ek bilgi
| Miktar | IBC |
|---|---|
| Raf Ömrü | 6 Ay |
Kargo & Teslimat
Kargo ve Teslimat
Tüm ürünleriniz özenle paketlenerek sizlere ulaştırılır.
Web sitemizden saat 14:30'a kadar vermiş olduğunuz siparişler aynı gün kargoya verilir.
Siparişleriniz yoğunluk durumuna bağlı olarak en geç 3 gün içerisinde adresinize ulaşmış olur.
Siparişlerinizle ilgili aklınıza takılan tüm soruları Müşteri Hizmetleri bölümümüzden bizlere sorabilirsiniz.

Bunlar da ilgini çekebilir
ChemKomplex 20 Litre
SKU:
585945-20
Chemya® Klordioksit 5 Litre
SKU:
34369-5
Klordioksit Biocid 30 Litre
SKU:
39855-30
Steridez® / Steriplus B Lejyonella 30 Litre
SKU:
40416-30
SteriPlus® Klordioksit 20 Litre
SKU:
40757-20
SteriPlus® Klordioksit 30 Litre
SKU:
40757-30















